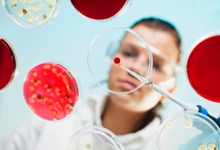

Messe-Nachlese

Plastic is Fantastic: Branchen-Momentum auf der K 2025
Die internationale Fachmesse für Kunststoff und Kautschuk in Düsseldorf war dieses Jahr mehr als ein Forum – sie wurde zur Bühne für eine neue Haltung der Kunststoffbranche. Dominic Fiel, Executive Director der Plastic is Fantastic Association, zieht Bilanz: “Die Messe hat unsere Erwartungen ganz klar übertroffen. Die Resonanz war überwältigend.”
Bereits in den ersten Stunden der Messe wurde klar: Die Besucher waren gespannt, interessiert und offen für den Auftritt der neu gegründeten “Plastic is Fantastic Association”.
Starke Botschaften, starke Reaktionen
“Die Stimmung am Stand war unglaublich positiv und energiegeladen”, freut sich Dominic Fiel. Besucher zeigten sich begeistert, dass endlich jemand proaktiv, selbstbewusst und mit klaren Fakten gegen das Kunststoff-Bashing vorgeht.
Ein besonderes Highlight war das Vereins-Maskottchen Captain Plasto, Dominic Fiel: “Unzählige Besucher haben Selfies und Gruppenfotos gemacht. Captain Plasto wurde zu einem echten Publikumsmagneten und Symbol für unsere Bewegung.”
Die Kernbotschaft der Association “Powerful Material. Powerful Voice.” traf auf offene Ohren – bei Partnern, Medien und Besuchern gleichermaßen. “Unsere Botschaft hat viele emotional wie rational erreicht. Medien und Partner haben sofort erkannt, dass dieser faktenbasierte Ansatz der Branche neue Energie verleiht”, erklärt Dominic Fiel.
Globale Vernetzung, klare Zukunftsstrategie
Häufige Themen an den Ständen waren Kreislaufwirtschaft, CO2-Bilanz und die aktive Mitgliedschaft in der Association: “Viele Besucher wollten verstehen, wie wir Wissenschaft, Kommunikation und Aufklärung verbinden, um Fehlinformationen fundiert entgegenzutreten.”
Besonders beeindruckt ist Dominic Fiel von der internationalen Aufmerksamkeit: “Kunststoffverbände aus der ganzen Welt – von Südamerika bis Neuseeland – haben aktiv ihre Zusammenarbeit angeboten. Das zeigt: Kunststoff verbindet Menschen über Länder, Sprachen und Märkte hinweg.”
Die K 2025 lieferte klare Impulse für die weitere Arbeit der Plastic is Fantastic Association. Executive Director Fiel: “Wir wollen dieses Momentum nutzen, um unsere globale Reichweite auszubauen, neue Allianzen zu schaffen und Kommunikationsformate zu entwickeln, die Wissen und Emotion verbinden. Der Zuspruch hat uns gezeigt, dass wir auf dem richtigen Weg sind – der Wunsch nach Aufklärung ist stärker denn je.” Dominic Fiel fasst zusammen: “Die K 2025 war ein starkes Signal: Die Kunststoffbranche ist bereit, selbstbewusst, vereint und faktenbasiert für ihre Bedeutung in einer nachhaltigen Zukunft einzustehen.”
Geballte Power, weiterer Auftritt
“Ganz sicher werden wir 2028 wieder an der K teilnehmen”, sagt Dominic Fiel. Und führt aus: “Dann möchten wir mit einer noch stärker gewachsenen und international etablierten Struktur zurückkehren – als globale Allianz, die faktenbasierte Aufklärung über Kunststoffe nachhaltig verankert hat. Unser Ziel ist es, bis dahin noch viel mehr Menschen rund um den Globus zu erreichen und vor allem Endkonsumenten die enormen Vorteile von Kunststoffen aufzuzeigen.” Der Executive Director blickt nach vorn: “Wir werden weiterhin auf Dialog, Wissenschaft und Emotion setzen – und das Momentum der K 2025 nutzen, um eine weltweite Bewegung zu formen. Plastic is Fantastic – Powerful Material. Powerful Voice. soll bis dahin nicht nur ein Motto sein, sondern ein klares Symbol für Aufklärung, Zusammenarbeit und Stolz auf das, was unsere Branche leistet.”
Bei “Plastic is Fantastic” geht es um die Beziehung zwischen dem Menschen und einem der elementarsten Bausteine der Zivilisation: Kunststoff. Die Initiative will mit sachlichen Beiträgen die Wertschätzung erreichen, die dem vielseitigen Material angemessen ist.
Mehr Informationen zu Plastic is Fantastic finden Sie hier: https://www.plasticisfantastic.info/de
Wenn Sie sich für unseren Verein interessieren, besuchen Sie uns gerne online unter www.pif-association.com.
Unternehmen, die an einer Zusammenarbeit interessiert sind, steht Dominic Fiel als Ansprechpartner zur Verfügung: dominic.fiel@pif-association.com
Firmenkontakt
Plastic is Fantastic Association
Dominic Fiel
Annagasse 6
1010 Wien
+43 5574602119
https://www.pif-association.com
Pressekontakt
yes or no Media GmbH
Claudia Wörner
Vor dem Lauch 4
70567 Stuttgart
+ 49 711 7585 8900
www.yesorno.de
Bildquelle: Plastic is Fantastic Association
AchtungFür den Inhalt des Artikels ist der jeweilige Autor und nicht der Seitenbetreiber verantwortlich. |